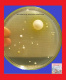

Se ha encontrado 212 resultados
Mostrando la pagina 2 de 11
- Publicar anuncios de reformas en Ecuador
- Publicar anuncios de construcción en Ecuador
- Publicar anuncios de fiestas en Ecuador
- Publicar anuncios de eventos en Ecuador
- Publicar anuncios de terapias en Ecuador
- Publicar anuncios de masajistas en Ecuador
- Publicar anuncios de relax en Ecuador
- Publicar anuncios de servicios en Ecuador
- Publicar anuncios de tarot en Ecuador
- Publicar anuncios de marketing en Ecuador
- Publicar anuncios de publicidad en Ecuador
- Publicar anuncios de viajes en Ecuador
- Publicar anuncios de turismo en Ecuador
- Publicar anuncios de prestamos en Ecuador
- Publicar anuncios de perros en Ecuador
- Publicar anuncios de animales en Ecuador
- Publicar anuncios de mascotas en Ecuador
- Publicar anuncios de gatos en Ecuador
- Publicar anuncios de mudanzas en Ecuador
- Publicar anuncios para electricistas en Ecuador
- Publicar anuncios para fontaneros en Ecuador
- Publicar anuncios para abogados en Ecuador
- Publicar anuncios de limpieza en Ecuador
- Publicar anuncios de jardineria en Ecuador
- Publicar anuncios de decoración en Ecuador
- Publicar anuncios de belleza en Ecuador
- Publicar anuncios de alquiler de vehiculos en Ecuador
- Publicar anuncios de alquiler de coches en Ecuador
- Publicar anuncios de alquiler de motos en Ecuador